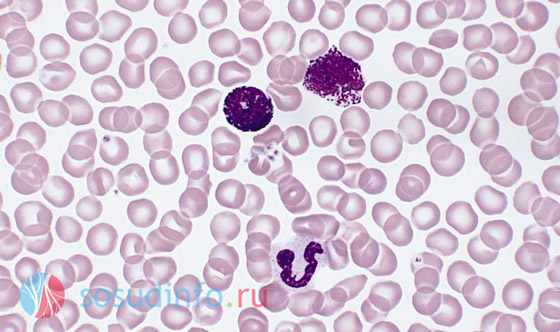
image

Возможные причины
Лейкопения возникает из-за воздействия экзо- или эндогенных факторов. Основные причины:
- недостаток веществ для лейкопоэза;
- быстрое разрушение лейкоцитов;
- неполноценное созревание и сбои в дифференциации клеток;
- заболевания или попадание определенных веществ в организм.
Лейкопения — это лабораторный термин, указывающий на нарушения в организме. Для нормализации иммунной функции необходимо выявить и устранить причину.
Дефицит веществ
Для синтеза всех кровяных клеток необходимы витамины (В1, В6, В9, В12, С) и минералы (медь, железо, кобальт, йод, марганец, цинк). Арахидоновая кислота, аминокислоты и селен также важны. Дефицит микроэлементов часто возникает при нарушениях питания.
При алиментарных нарушениях уровень лейкоцитов обычно падает незначительно. Если сбои не вызваны серьезными заболеваниями, лейкопению можно скорректировать диетой.
Проблемы с костным мозгом
Все типы кровяных клеток синтезируются в костном мозге. Сбои в работе лейкопоэтической системы могут происходить при:
- интоксикациях (острых и хронических);
- онкологических заболеваниях;
- врожденных патологиях (миелокатексис, болезнь Костманна);
- приеме некоторых препаратов (химиотерапия, интерферон).
Если проблема в костном мозге, отклонения показателей крови будут значительными и устойчивыми к диете.
Усиленная гибель клеток
Лейкоциты первыми реагируют на инфекции и аллергенные агенты. При локальных изменениях возможны значительные потери клеток. Отклонения также могут возникать при длительных бактериальных и вирусных инфекциях (грипп, гепатит, пневмония) и интоксикациях.
Заболевания внутренних органов
При инфекциях иммунитет активизируется, но при длительном развитии патологии может произойти истощение запасов лейкоцитов. Это наблюдается при:
- онкологических заболеваниях;
- вирусных инфекциях (цитомегаловирус, грипп, ВИЧ);
- осложнениях бактериальных инфекций (пневмония, сепсис);
- нарушениях функции щитовидной железы;
- паразитарных инвазиях;
- аутоиммунных заболеваниях (склеродермия, системная красная волчанка).
Состояние печени и селезенки также влияет на уровень лейкоцитов.
Лекарственные препараты
Химиотерапия может подавлять активность иммунной системы и замедлять выход лейкоцитов из депо. Лейкопения может развиться при длительном применении нестероидных противовоспалительных средств, антидепрессантов и других препаратов.
Как поднять лейкоциты после химиотерапии
Химиотерапия негативно влияет на кровеносную систему, снижая уровень гемоглобина и лейкоцитов. Для повышения уровня лейкоцитов после лечения применяются препараты-стимуляторы метаболических процессов и колониестимулирующие факторы.
Эффективные средства:
- Пентоксил — стимулирует выработку лейкоцитов и клеточное восстановление.
- Лейкоген — увеличивает количество белых клеток, минимально токсичен.
- Лейкомакс — инъекционный стимулятор лейкопоэза.
- Метилурацил — активирует лейкопоэз, курс 7-30 дней.
- Филграстим — внутривенные или подкожные инъекции для повышения лейкоцитов.
- Нейпоген — высокоочищенный белок для пациентов на химиотерапии.
- Ленограстим — восстанавливает кроветворение после химиотерапии.

Важно следить за самочувствием и температурой тела. При повышении температуры выше 38°С необходимо обратиться к врачу. Следует избегать людных мест во время эпидемий и тщательно следить за гигиеной полости рта.
Нормализация уровня лейкоцитов требует комплексного подхода, включая медикаменты и специализированное питание.
Что означают отклонения в анализах
Снижение уровня лейкоцитов до 310⁹/л и нейтрофилов до 110⁹/л требует немедленного обращения к врачу. Внимание также требует нарушение нормы лейкоцитов и тромбоцитов.
Существенное снижение лейкоцитов указывает на серьезные расстройства, повышая восприимчивость к инфекциям и осложнениям. Это может свидетельствовать о сбоях в кроветворной функции или прогрессировании рака.
Нейтропения
Снижение нейтрофилов до 1*10⁹/л может сопровождать вирусные и бактериальные инфекции, указывать на осложнения системных заболеваний и наблюдаться у алкоголиков.
Анэозинофилия
Уменьшение эозинофилов ниже 0,2*10⁹/л связано с септицемией, острыми инфекциями и сильными интоксикациями.
Базопения
Недостаток базофилов (менее 0,01*10⁹/л) сложно оценить, так как они присутствуют в крови в малом количестве. Критическое снижение наблюдается при синдроме Кушинга и гипертиреозе.
Лимфопения
Недостаток лимфоцитов указывает на серьезные угрозы здоровью, часто встречается при иммунодефицитах. Снижение до 1*10⁹/л у взрослых свидетельствует о тяжелых дисфункциях иммунитета.
Моноцитопения
Состояние, при котором уровень моноцитов не превышает 0,09*10⁹/л, может развиваться на фоне гормональной терапии и некоторых форм лейкоза.
Диеты
Людям с ослабленным иммунитетом следует соблюдать диету, способствующую увеличению числа белых кровяных клеток.
Продукты, повышающие лейкоциты
- Витамин С — способствует выработке лейкоцитов. Источники: болгарский перец, брокколи, цитрусовые.
- Витамин Е — поддерживает здоровье иммунной системы. Источники: миндаль, оливки, семечки.
- Каротиноиды — увеличивают выработку лейкоцитов. Источники: морковь, тыква, шпинат.
- Витамин B12 — способствует увеличению лейкоцитов. Источники: говядина, моллюски.
- Цинк — усиливает действие лейкоцитов. Источники: устрицы, говядина, бобы.
Негативные факторы
Чрезмерное потребление сахара и алкоголя, а также плохие привычки могут снижать уровень лейкоцитов. Регулярные физические упражнения способствуют укреплению иммунной системы.
P.S. БАДы могут помочь увеличить количество лейкоцитов, но их следует принимать только после консультации с врачом.
Функция и типы лейкоцитов
Лейкоциты играют ключевую роль в защите организма от инфекций. Они реагируют на внедрение патогенов, концентрируясь вокруг них и уничтожая. У здорового человека уровень лейкоцитов в крови колеблется от 5 000 до 10 000 на микролитр.
Длительное снижение уровня лейкоцитов повышает риск заболеваний, так как организм становится уязвимым к инфекциям.
Факторы, влияющие на снижение количества белых клеток
Лейкоциты образуются в красном костном мозге и лимфатических узлах. Пониженный уровень лейкоцитов (лейкопения) может указывать на нарушения в работе костного мозга или саморазрушение клеток.
Причины лейкопении делятся на первичные и вторичные:
- Первичные: врожденные недуги, онкологические заболевания, нехватка витамина В, лучевая болезнь, ВИЧ, аутоиммунные заболевания.
- Вторичные: вирусные инфекции, повышенная активность щитовидной железы, болезни печени и селезенки, аутоиммунные заболевания.
Лейкоциты могут снижаться из-за приема медикаментов, включая химиотерапевтические препараты и некоторые анальгетики.
Нарушения кроветворения
Наиболее опасной причиной лейкопении является нарушение образования белых клеток, связанное с серьезными заболеваниями, такими как:
- тяжелые отравления;
- опухоли костного мозга;
- лучевая болезнь;
- ВИЧ-инфекция;
- аутоиммунные заболевания.
Чем вызывается лейкопения
Причины падения числа белых клеток делятся на пять категорий:
- Нехватка элементов для производства лейкоцитов.
- Патологии костного мозга.
- Интоксикации.
- Заболевания внутренних органов.
- Прием фармацевтических препаратов.
Нехватка необходимых веществ
Для производства белых клеток необходимы витамины и микроэлементы (тиамин, кобаламин, фолиевая кислота, медь, железо). Если их недостаточно, уровень лейкоцитов снижается.
Заболевания костного мозга
К заболеваниям, приводящим к лейкопении, относятся:
- врожденные патологии;
- злокачественные опухоли;
- метастазы в костный мозг.
Интоксикация
Лейкоциты могут снижаться после интоксикации, вызванной наркотиками, алкоголем или химическими веществами.
Заболевания внутренних органов
При воспалительных заболеваниях лейкоциты могут устремляться к месту инфекции, что приводит к их снижению в крови.
Медпрепараты
Некоторые лекарства могут значительно снижать уровень лейкоцитов, включая анальгетики, цитостатики и противоаллергические препараты.
Как повысить иммунитет народными средствами?
Народная медицина предлагает различные рецепты для повышения уровня лейкоцитов, в зависимости от причины отклонений.
Примеры:
- Отвар льна: 4 ст.л. семян на 2 литра кипятка, принимать в течение месяца.
- Настой душицы: 1 ст.л. на стакан кипятка.
- Сок бобовых: свежий сок из незрелых стручков фасоли.
- Настой полыни: 3 ст.л. на три стакана кипятка.
При любом лечении важно контролировать уровень лейкоцитов с помощью анализов.
Разновидности лейкопении
Лейкопения делится на острые и хронические формы. Хронические формы подразделяются на перераспределительную, иммунную и идиопатическую.
- Перераспределительная — задержка лейкоцитов в капиллярах.
- Иммунная — возникает при частом использовании антибиотиков.
- Идиопатическая — бессимптомная форма, не связанная с нарушениями в костном мозге.